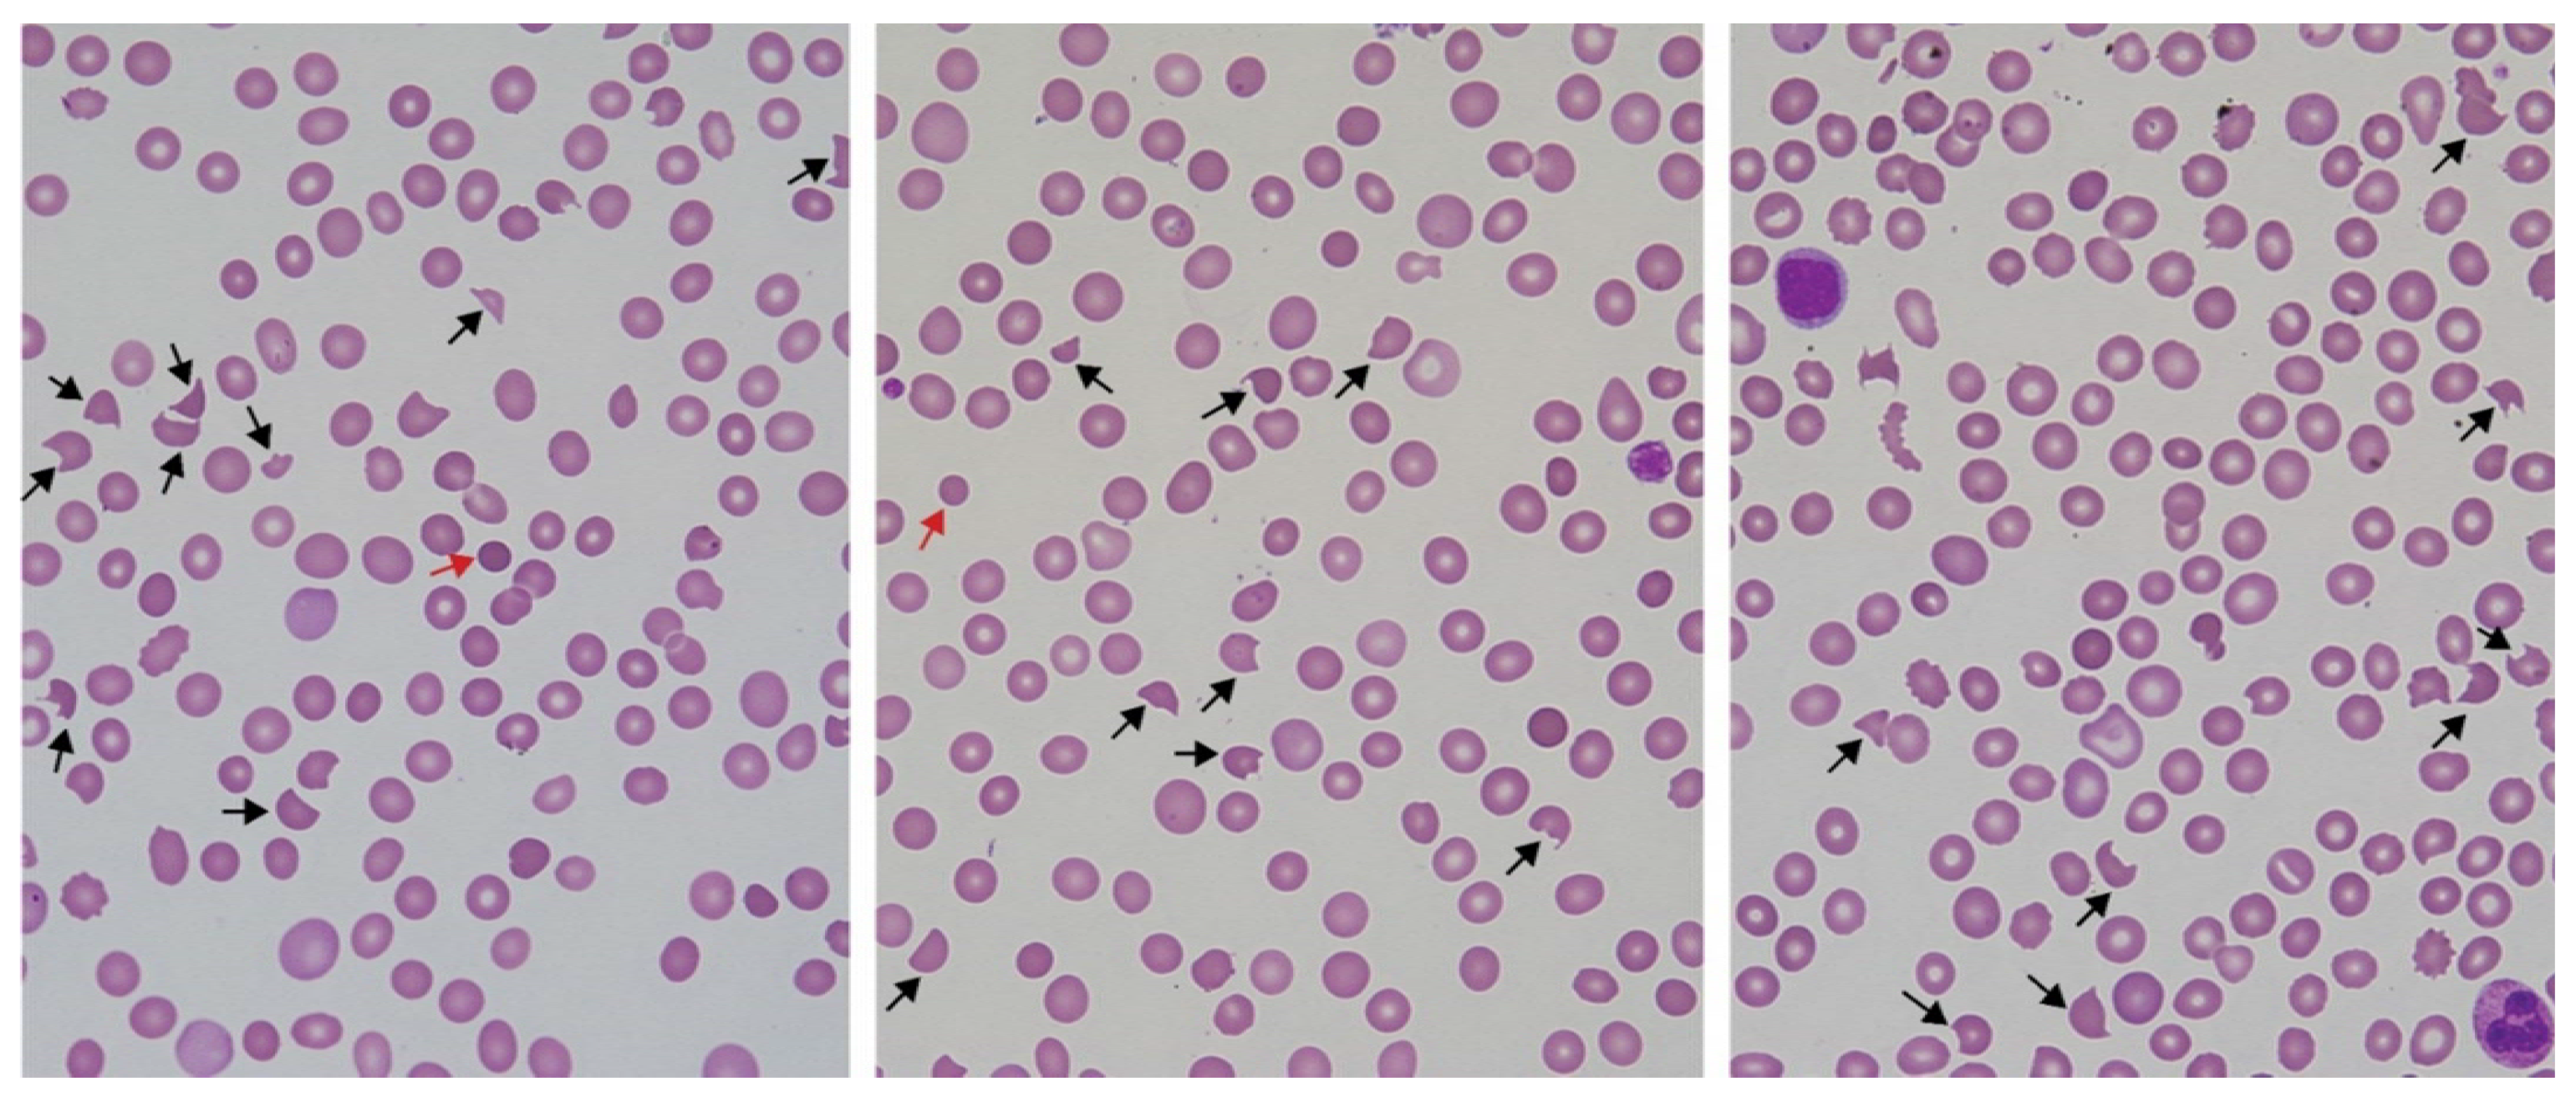
Toxins 14 00057 g002

Snakebite Associated Thrombotic Microangiopathy and Recommendations for Clinical Practice
Abstract
:1. Introduction
2. Epidemiology
3. Association with Envenoming by Snake Genera/Species Causing VICC
4. Snakebite Associated TMA Is Defined by MAHA and Thrombocytopenia
5. Peripheral Blood Film Examination for Schistocyte Quantitation as a Diagnostic Tool for Snakebite-Associated TMA
6. Acute Kidney Injury Is the Predominant End Organ Damage in Snakebite-Associated TMA
7. In Hospital Outcomes: Overall Survival and Dialysis Free Survival
8. Role of Interventions: Antivenom and TPE
9. Long-Term Survival and Risk of CKD
10. The Aetiology of Snakebite Associated TMA Remains Unclear, but It Is Not DIC, TTP, or HUS
11. Conclusions and Recommendations for Practice
- Snakebite-associated TMA should not be included within inclusion criteria for DIC diagnostic scoring systems;
- The terms TTP and HUS should not be used in association with snakebite. Snakebite should be considered as a condition associated with secondary TMA, but distinct from both TTP and HUS. The preferred term is snakebite-associated TMA, or alternatively, TMA secondary to snakebite;
- Where resources allow, a manual blood film for quantitation of schistocytes is recommended in all patients presenting with snakebite envenoming and VICC from haemo-toxic snakebites. It is recognised that this will not always be possible in the global settings where snakebite is a significant public health issue. In this instance serial creatinine testing, and/or careful observation of urine output are important for the detection of AKI, the main end organ injury of snakebite associated TMA;
- A definition of snakebite-associated TMA consisting of MAHA with ≥1.0% schistocytes, together with either thrombocytopenia (platelets < 150 × 109/L) or a >25% decrease in platelets from baseline, is recommended. When applying this definition, it must be recognised that this is a spectrum disorder and that there is a very small subset of outliers at risk of AKI who will not meet all features of this definition;
- While evidence for a role of antivenom in the prevention of TMA in patients presenting with VICC is unclear, early intervention with antivenom at the first sign of envenoming remains the standard of care in snakebite;
- TPE for snakebite-associated TMA cannot be recommended for routine medical practice. This is consistent with most other types of toxin- or drug-associated TMA. Whilst the role for TPE in TTP is indisputable, there is generally either uncertain evidence for benefit, or evidence which demonstrates that TPE is either ineffective or harmful in most secondary causes of TMA not associated with ADAMTS-13 deficiency, such as snakebite [24];
- Globally, resources for the care of patients with suspected or confirmed snakebite-associated TMA should be directed towards best supportive care. This is particularly critical in low resource settings including the rural and impoverished regions of the world where snakebite is most common. Supportive care includes antivenom for envenomed patients; judicious attention to measures which mitigate exposures to additional renal insults such as volume depletion, haemo-dynamic instability and nephrotoxic drugs; intensive care as required; and dialysis when needed and as local resources allow. Patients may require intensive care support for other clinical toxicities of snakebite such as neurotoxic paralysis, and stabilisation to avoid other contributors to renal injury including hypotension;
- As with other causes of AKI, patients with TMA are at risk of subsequent CKD after initial recovery and long-term follow-up is strongly recommended. This should include monitoring of renal function, avoidance and management of other renal risk factors, and CKD management as required.
Author Contributions
Funding
Institutional Review Board Statement
Informed Consent Statement
Data Availability Statement
Conflicts of Interest
References
- Snakebite Envenoming: A Strategy for Prevention and Control; World Health Organization: Geneva, Switzerland, 2019; Available online: https://apps.who.int/iris/bitstream/handle/10665/324838/9789241515641-eng.pdf?ua=1 (accessed on 28 November 2021).
- Fantom, N.; Serajuddin, U. The World Bank’s Classification of Countries by Income; Policy Research Working Paper; No. 7528; World Bank: Washington, DC, USA, 2016; Available online: https://openknowledge.worldbank.org/handle/10986/23628 (accessed on 28 November 2021).
- Gutiérrez, J.M.; Calvete, J.; Habib, A.G.; Harrison, R.A.; Williams, D.; Warrell, D.A. Snakebite envenoming. Nat. Rev. Dis. Prim. 2017, 3, nrdp201763. [Google Scholar] [CrossRef]
- Slagboom, J.; Kool, J.; Harrison, R.; Casewell, N.R. Haemotoxic snake venoms: Their functional activity, impact on snakebite victims and pharmaceutical promise. Br. J. Haematol. 2017, 177, 947–959. [Google Scholar] [CrossRef] [PubMed] [Green Version]
- Maduwage, K.; Isbister, G.K. Current Treatment for Venom-Induced Consumption Coagulopathy Resulting from Snakebite. PLoS Negl. Trop. Dis. 2014, 8, e3220. [Google Scholar] [CrossRef] [Green Version]
- Tasoulis, T.; Isbister, G.K. A Review and Database of Snake Venom Proteomes. Toxins 2017, 9, 290. [Google Scholar] [CrossRef] [PubMed] [Green Version]
- Berling, I.; Isbister, G. Hematologic Effects and Complications of Snake Envenoming. Transfus. Med. Rev. 2015, 29, 82–89. [Google Scholar] [CrossRef]
- Scully, M.; Cataland, S.; Coppo, P.; De La Rubia, J.; Friedman, K.D.; Hovinga, J.A.K.; Lämmle, B.; Matsumoto, M.; Pavenski, K.; Sadler, E.; et al. Consensus on the standardization of terminology in thrombotic thrombocytopenic purpura and related thrombotic microangiopathies. J. Thromb. Haemost. 2017, 15, 312–322. [Google Scholar] [CrossRef] [PubMed] [Green Version]
- George, J.N.; Nester, C.M. Syndromes of thrombotic microangiopathy. N. Engl. J. Med. 2014, 371, 654–666. [Google Scholar] [CrossRef] [Green Version]
- Chugh, K. Snake-bite-induced acute renal failure in India. Kidney Int. 1989, 35, 891–907. [Google Scholar] [CrossRef] [Green Version]
- Herath, N.; Wazil, A.; Kularatne, S.A.M.; Ratnatunga, N.; Weerakoon, K.; Badurdeen, S.; Rajakrishna, P.; Nanayakkara, N.; Dharmagunawardane, D. Thrombotic microangiopathy and acute kidney injury in hump-nosed viper (Hypnale species) envenoming: A descriptive study in Sri Lanka. Toxicon 2012, 60, 61–65. [Google Scholar] [CrossRef]
- Ho, W.K.; Verner, E.; Dauer, R.; Duggan, J. ADAMTS-13 activity, microangiopathic haemolytic anaemia and thrombocytopenia following snake bite envenomation. Pathology 2010, 42, 200–202. [Google Scholar] [CrossRef]
- Dhanapriya, J.; Dineshkumar, T.; Sakthirajan, R.; Thirumalvalavan, K.; Kurien, A.A.; Balasubramaniyan, T.; Gopalakrishnan, N. Thrombotic microangiopathy due to Viperidae bite: Two case reports. Indian J. Nephrol. 2017, 27, 161–164. [Google Scholar] [CrossRef] [PubMed]
- Johnston, C.I.; Ryan, N.M.; Page, C.B.; Buckley, N.A.; Brown, S.G.; O’Leary, M.A.; Isbister, G.K. The Australian Snakebite Project, 2005–2015 (ASP-20). Med. J. Aust. 2017, 207, 119–125. [Google Scholar] [CrossRef]
- Wijewickrama, E.S.; Gooneratne, L.V.; Gnanathasan, A.; Gawarammana, I.; Gunatilake, M.; Isbister, G.K. Thrombotic microangiopathy and acute kidney injury following Sri Lankan Daboia russelii and Hypnale species envenoming. Clin. Toxicol. 2020, 58, 997–1003. [Google Scholar] [CrossRef]
- Wijewickrama, E.S.; Gooneratne, L.V.; Gnanathasan, A.; Gawarammana, I.; Gunatilake, M.; Isbister, G.K. Severe acute kidney injury following Sri Lankan Hypnale spp. envenoming is associated with thrombotic microangiopathy. Clin. Toxicol. 2021, 59, 296–302. [Google Scholar] [CrossRef] [PubMed]
- Isbister, G.; Little, M.; Cull, G.; McCoubrie, D.; Lawton, P.; Szabo, F.; Kennedy, J.; Trethewy, C.; Luxton, G.; Brown, S.; et al. Thrombotic microangiopathy from Australian brown snake (Pseudonaja) envenoming. Intern. Med. J. 2007, 37, 523–528. [Google Scholar] [CrossRef] [PubMed]
- Cobcroft, R.G.; Williams, A.; Cook, D.; Williams, D.J.; Masci, P. Hemolytic uremic syndrome following taipan envenomation with response to plasmapheresis. Pathology 1997, 29, 399–402. [Google Scholar] [CrossRef]
- Rathnayaka, R.N.; Ranathunga, P.A.N.; Kularatne, S.A. Thrombotic Microangiopathy, Hemolytic Uremic Syndrome, and Thrombotic Thrombocytopenic Purpura Following Hump-nosed Pit Viper (Genus: Hypnale) Envenoming in Sri Lanka. Wilderness Environ. Med. 2019, 30, 66–78. [Google Scholar] [CrossRef] [Green Version]
- Casamento, A.J.; Isbister, G. Thrombotic Microangiopathy in Two Tiger Snake Envenomations. Anaesth. Intensiv. Care 2011, 39, 1124–1127. [Google Scholar] [CrossRef]
- Keyler, D.E. Envenomation by the lowland viper (Proatheris superciliaris): Severe case profile documentation. Toxicon 2008, 52, 836–841. [Google Scholar] [CrossRef]
- Withana, M.; Rodrigo, C.; Gnanathasan, A.; Gooneratne, L. Presumptive thrombotic thrombocytopenic purpura following a hump-nosed viper (Hypnale hypnale) bite: A case report. J. Venom. Anim. Toxins Incl. Trop. Dis. 2014, 20, 1–11. [Google Scholar] [CrossRef] [Green Version]
- Obeidat, M.B.; Al-Swailmeen, A.M.; Al-Sarayreh, M.M.; Rahahleh, K.M. Thrombotic Microangiopathy Following Arabian Saw-Scaled Viper (Echis coloratus) Bite: Case Report. Am. J. Case Rep. 2020, 21, e922000-1–e922000-5. [Google Scholar] [CrossRef] [PubMed]
- Winters, J.L. Plasma exchange in thrombotic microangiopathies (TMAs) other than thrombotic thrombocytopenic purpura (TTP). Hematology 2017, 2017, 632–638. [Google Scholar] [CrossRef] [Green Version]
- Zakarija, A.; McCaffrey, B.K.R.; Bandarenko, N.; Pandey, D.; Cursio, M.J.; Tevar, M.A.; Kwaan, H.; Yarnold, P.R.; Burton, M.; Bennett, C.L. Incident TTP: Plasmapheresis Therapy-Related Complications Are Common. Blood 2005, 106, 563–566. [Google Scholar] [CrossRef]
- Szczeklik, W.; Wawrzycka, K.; Włudarczyk, A.; Sega, A.; Nowak, I.; Seczyńska, B.; Fajfer, I.; Zając, K.; Królikowski, W.; Kózka, M. Complications in patients treated with plasmapheresis in the intensive care unit. Anestezjol. Intensywna Ter. 2013, 45, 7–13. [Google Scholar] [CrossRef]
- Rahmani, T.I.; Nasasra, T.; Fuchs, L.; Almog, Y.; Lurie, Y.; Galante, O. Acute thrombotic microangiopathic kidney injury due to Echis coloratus envenomation. Clin Toxicol. 2020, 58, 284–286. [Google Scholar] [CrossRef] [PubMed]
- Rao, I.R.; Prabhu, R.; Nagaraju, S.P.; Rangaswamy, D. Thrombotic Microangiopathy: An Under-Recognised Cause of Snake-bite-related Acute Kidney Injury. Indian J. Nephrol. 2019, 29, 324–328. [Google Scholar] [CrossRef]
- Noutsos, T.; Currie, B.J.; Isoardi, K.Z.; Brown, S.G.A.; Isbister, G.K. Snakebite-associated thrombotic microangiopathy: An Australian prospective cohort study [ASP30]. Clin. Toxicol. 2021. [Google Scholar] [CrossRef] [PubMed]
- Noutsos, T.; Currie, B.J.; Lek, R.A.; Isbister, G.K. Snakebite associated thrombotic microangiopathy: A systematic review of clinical features, outcomes, and evidence for interventions including plasmapheresis. PLoS Negl. Trop. Dis. 2020, 14, e0008936. [Google Scholar] [CrossRef]
- Mohan, G.; Guduri, P.R.; Shastry, S.; Kandasamy, D. Thrombotic microangiopathy in hematotoxic snakebites and its impact on the prognosis: An entity often overlooked. J. Thromb. Thrombolysis 2019, 48, 475–482. [Google Scholar] [CrossRef]
- Rathnayaka, R.M.M.K.N.; Ranathunga, P.E.A.N.; Kularatne, S.A.M. Kidney injury following envenoming by hump-nosed pit viper (Genus:Hypnale) in Sri Lanka: Proven and probable cases. Trans. R. Soc. Trop. Med. Hyg. 2019, 113, 131–142. [Google Scholar] [CrossRef]
- Dorgalaleh, A.; Favaloro, E.J.; Bahraini, M.; Rad, F. Standardization of Prothrombin Time/International Normalized Ratio (PT/INR). Int. J. Lab. Hematol. 2021, 43, 21–28. [Google Scholar] [CrossRef]
- Isbister, G.K.; Scorgie, F.E.; O’Leary, M.A.; Seldon, M.; Brown, S.G.A.; Lincz, L.F.; FOR THE ASP INVESTIGATORS. Factor deficiencies in venom-induced consumption coagulopathy resulting from Australian elapid envenomation: Australian Snakebite Project (ASP-10). J. Thromb. Haemost. 2010, 8, 2504–2513. [Google Scholar] [CrossRef] [PubMed]
- Date, A.; Pulimood, R.; Jacob, C.; Kirubakaran, M.; Shastry, J. Haemolytic-Uraemic Syndrome Complicating Snake Bite. Nephron 1986, 42, 89–90. [Google Scholar] [CrossRef]
- Junior, R.M.; Jorge, M.T.; de Campos, F.P.; Martins, F.P.; Bousso, A.; Cardoso, J.L.; Ribeiro, L.A.; Fan, H.W.; França, F.O.; Sano-Martins, I.S.; et al. Snake bites by the jararacucu (Bothrops jararacussu): Clinicopathological studies of 29 proven cases in Sao Paulo State, Brazil. QJM Int. J. Med. 1997, 90, 323–334. [Google Scholar] [CrossRef] [PubMed] [Green Version]
- Mittal, B.V. Acute renal failure following poisonous snake bite. J. Postgrad. Med. 1994, 40, 123. [Google Scholar] [PubMed]
- Warrell, D.A.; Davidson, N.M.; Greenwood, B.M.; Ormerod, L.D.; Pope, H.M.; Watkins, B.J.; Prentice, C.R.M. Poisoning by Bites of the Saw-Scaled or Carpet Viper (Echis carinatus) in Nigeria. QJM Int. J. Med. 1977, 46, 33–62. [Google Scholar] [CrossRef]
- Punguyire, D.; Iserson, K.V.; Stolz, U.; Apanga, S. Bedside Whole-Blood Clotting Times: Validity after Snakebites. J. Emerg. Med. 2013, 44, 663–667. [Google Scholar] [CrossRef] [PubMed]
- Dsilva, A.A.; Basheer, A.; Thomas, K. Snake envenomation: Is the 20 min whole blood clotting test (WBCT20) the optimum test for management? QJM Int. J. Med. 2019, 112, 575–579. [Google Scholar] [CrossRef]
- Isbister, G.K.; Maduwage, K.; Shahmy, S.; Mohamed, F.; Abeysinghe, C.; Karunathilake, H.; Ariaratnam, C.A.; Buckley, N. Diagnostic 20-min whole blood clotting test in Russell’s viper envenoming delays antivenom administration. QJM Int. J. Med. 2013, 106, 925–932. [Google Scholar] [CrossRef] [Green Version]
- Maduwage, K. Snakebite coagulopathy: Controversies in understanding and management. Sri Lanka J. Med. 2018, 26, 38–54. [Google Scholar] [CrossRef]
- Maduwage, K.; Scorgie, F.; Silva, A.; Shahmy, S.; Mohamed, F.; Abeysinghe, C.; Karunathilake, H.; Lincz, L.; Gnanathasan, C.A.; Isbister, G.K. Hump-nosed pit viper (Hypnale hypnale) envenoming causes mild coagulopathy with incomplete clotting factor consumption. Clin. Toxicol. 2013, 51, 527–531. [Google Scholar] [CrossRef]
- Noutsos, T.; Currie, B.J.; Brown, S.G.; Isbister, G.K. Schistocyte quantitation, thrombotic microangiopathy and acute kidney injury in Australian snakebite coagulopathy [ASP28]. Int. J. Lab. Hematol. 2021, 43, 959–965. [Google Scholar] [CrossRef]
- Ireland, G.; Brown, S.; Buckley, N.; Stormer, J.; Currie, B.J.; White, J.; Spain, D.; Isbister, G. Changes in serial laboratory test results in snakebite patients: When can we safely exclude envenoming? Med. J. Aust. 2010, 193, 285–290. [Google Scholar] [CrossRef] [PubMed] [Green Version]
- Isbister, G.K. Procoagulant snake toxins: Laboratory studies, diagnosis and understanding snake bite coagulopathy. Semin. Thromb. Hemostasis 2009, 35, 93–103. [Google Scholar] [CrossRef] [PubMed]
- Weiss, H.J.; Phillips, L.L.; Hopewell, W.S.; Phillips, G.; Christy, N.P.; Nitti, J.F. Heparin therapy in a patient bitten by a saw-scaled viper (Echis carinatus), a snake whose venom activates prothrombin. Am. J. Med. 1973, 54, 653–662. [Google Scholar] [CrossRef]
- Hatten, B.W.; Bueso, A.; French, L.K.; Hendrickson, R.G.; Horowitz, B.Z. Envenomation by the great lakes bush viper (Atheris nitschei). Clin. Toxicol. 2013, 51, 114–116. [Google Scholar] [CrossRef] [PubMed]
- Warrell, D.A.; Ormerod, L.D.; Davidson, N.M. Bites by puff-adder (Bitis arietans) in Nigeria, and value of antivenom. BMJ 1975, 4, 697–700. [Google Scholar] [CrossRef] [Green Version]
- Schneemann, M.; Cathomas, R.; Laidlaw, S.; El Nahas, A.; Theakston, R.; Warrell, D. Life-threatening envenoming by the Saharan horned viper (Cerastes cerastes) causing micro-angiopathic haemolysis, coagulopathy and acute renal failure: Clinical cases and review. QJM Int. J. Med. 2004, 97, 717–727. [Google Scholar] [CrossRef]
- Amaral, C.; Da Silva, O.; Godoy, P.; Miranda, D. Renal cortical necrosis following Bothrops jararaca and B. jararacussu snake bite. Toxicon 1985, 23, 877–885. [Google Scholar] [CrossRef]
- Isbister, G.K. Snakebite Doesn’t Cause Disseminated Intravascular Coagulation: Coagulopathy and Thrombotic Microangi-opathy in Snake Envenoming. Semin. Thromb. Hemost. 2010, 36, 444–451. [Google Scholar] [CrossRef]
- Zini, G.; D’Onofrio, G.; Briggs, C.; Erber, W.; Jou, J.M.; Lee, S.H.; McFADDEN, S.; Vives-Corrons, J.L.; Yutaka, N.; Lesesve, J.F. ICSH recommendations for identification, diagnostic value, and quantitation of schistocytes. Int. J. Lab. Hematol. 2011, 34, 107–116. [Google Scholar] [CrossRef]
- Zini, G.; D’Onofrio, G.; Erber, W.N.; Lee, S.; Nagai, Y.; Basak, G.W.; Lesesve, J.; International Council for Standardization in Hematology (ICSH). 2021 update of the 2012 ICSH Recommendations for identification, diagnostic value, and quantitation of schistocytes: Impact and revisions. Int. J. Lab. Hematol. 2021, 43, 1264–1271. [Google Scholar] [CrossRef] [PubMed]
- Noutsos, T.; Laidman, A.Y.; Survela, L.; Arvanitis, D.; Segalla, R.; Brown, S.G.; Isbister, G.K. An evaluation of existing manual blood film schistocyte quantitation guidelines and a new proposed method. Pathology 2021, 53, 746–752. [Google Scholar] [CrossRef]
- Burns, E.R.; Lou, Y.; Pathak, A. Morphologic diagnosis of thrombotic thrombocytopenic purpura. Am. J. Hematol. 2004, 75, 18–21. [Google Scholar] [CrossRef] [PubMed]
- Lesesve, J.-F.; Salignac, S.; Alla, F.; Defente, M.; Benbih, M.; Bordigoni, P.; Lecompte, T. Comparative Evaluation of Schistocyte Counting by an Automated Method and by Microscopic Determination. Am. J. Clin. Pathol. 2004, 121, 739–745. [Google Scholar] [CrossRef]
- Schapkaitz, E.; Mezgebe, M.H. The clinical significance of schistocytes: A prospective evaluation of the International Council for Standardisation in Haematology schistocyte guidelines. Turk J. Hematol. 2017, 34, 59–63. [Google Scholar] [CrossRef] [PubMed]
- O’Brien, T.E.; Bowman, L.; Hong, A.; Goparaju, K. Quantification of Schistocytes from the Peripheral Blood Smear in Thrombotic Thrombocytopenic Purpura (TTP) Compared to Non-TTP Thrombocytopenic Hospitalized Patients. Blood 2018, 132, 4983. [Google Scholar] [CrossRef]
- Lesesve, J.-F.; Lecompte, T.; Alla, F.; Fenneteau, O.; Cynober, T.; Siest, J.-P.; Troussard, X.; Flandrin, G.; (Gfhc), G.F.D.C. Reproductibility of the morphological identification of schisocytes and evaluation of non observer-dependent methods. Ann. Biol. Clin. 2005, 63, 279–289. [Google Scholar]
- Huh, H.J.; Chung, J.W.; Chae, S.L. Microscopic schistocyte determination according to International Council for Standardization in Hematology recommendations in various diseases. Int. J. Lab. Hematol. 2013, 35, 542–547. [Google Scholar] [CrossRef] [PubMed]
- Lesesve, J.-F.; Martin, M.; Banasiak, C.; André-Kerneïs, E.; Bardet, V.; Lusina, D.; Kharbach, A.; Geneviève, F.; Lecompte, T. Schistocytes in disseminated intravascular coagulation. Int. J. Lab. Hematol. 2014, 36, 439–443. [Google Scholar] [CrossRef]
- Moiseev, I.S.; Tsvetkova, T.; Aljurf, M.; Alnounou, R.M.; Bogardt, J.; Chalandon, Y.; Drokov, M.Y.; Dvirnyk, V.; Faraci, M.; Friis, L.S.; et al. Clinical and morphological practices in the diagnosis of transplant-associated microangiopathy: A study on behalf of Transplant Complications Working Party of the EBMT. Bone Marrow Transplant. 2018, 54, 1022–1028. [Google Scholar] [CrossRef] [PubMed]
- World Health Organization. First WHO Model List of Essential In Vitro Diagnostics; World Health Organization: Geneva, Switzerland, 2019; p. 1017. Available online: https://www.who.int/publications/i/item/9789241210263 (accessed on 28 November 2021).
- World Health Organization, Research UNUWBWSPf, Training in Tropical D. Microscopy for the Detection, Identification and Quantification of Malaria Parasites on Stained Thick and Thin Blood Films in Research Settings (Version 1.0): Procedure: Methods Manual; World Health Organization: Geneva, Switzerland, 2015. [Google Scholar]
- World Health Organization. Bench Aids for the Morphological Diagnosis of Anaemia; World Health Organization: Geneva, Switzerland, 2001. [Google Scholar]
- Malbranque, S.; Piercecchi-Marti, M.D.; Thomas, L.; Barbey, C.; Courcier, D.; Bucher, B.; Ridarch, A.; Smadja, D.; Warrell, D.A. Case report: Fatal diffuse thrombotic microangiopathy after a bite by the “fer-de-lance” pit viper (Bothrops lanceolatus) of Martinique. Am. J. Trop. Med. Hyg. 2008, 78, 856–861. [Google Scholar] [CrossRef] [PubMed] [Green Version]
- Kidney Disease: Improving Global Outcomes Acute Kidney Injury Working Group. KDIGO clincical practice guideline for acute kidney injury section 2: AKI definition. Kidney Int. Suppl. 2012, 2, 19–36. [Google Scholar] [CrossRef] [Green Version]
- Susantitaphong, P.; Cruz, D.N.; Cerda, J.; Abulfaraj, M.; Alqahtani, F.; Koulouridis, I.; Jaber, B.L. World Incidence of AKI: A Meta-Analysis. Clin. J. Am. Soc. Nephrol. 2013, 8, 1482–1493. [Google Scholar] [CrossRef] [Green Version]
- Ronco, C.; Bellomo, R.; Kellum, J.A. Acute kidney injury. Lancet 2019, 394, 1949–1964. [Google Scholar] [CrossRef]
- Levey, A.S.; James, M.T. Acute kidney injury. Ann. Intern. Med. 2017, 167, ITC66–ITC80. [Google Scholar] [CrossRef]
- Chawla, L.S.; Bellomo, R.; Bihorac, A.; Goldstein, S.L.; Siew, E.D.; Bagshaw, S.M.; Bittleman, D.; Cruz, D.; Endre, Z.; Fitzgerald, R.L.; et al. Acute kidney disease and renal recovery: Consensus report of the Acute Disease Quality Initiative (ADQI) 16 Workgroup. Nat. Rev. Nephrol. 2017, 13, 241–257. [Google Scholar] [CrossRef] [Green Version]
- Shah, S.R.; Tunio, S.A.; Arshad, M.H.; Moazzam, Z.; Noorani, K.; Feroze, A.M.; Shafquat, M.; Hussain, H.S.; Jeoffrey, S.A.H. Acute Kidney Injury Recognition and Management: A Review of the Literature and Current Evidence. Glob. J. Health Sci. 2015, 8, 120–124. [Google Scholar] [CrossRef]
- Ratnayake, I.; Mohamed, F.; Buckley, N.; Gawarammana, I.B.; Dissanayake, D.M.; Chathuranga, U.; Munasinghe, M.; Maduwage, K.; Jayamanne, S.; Endre, Z.H.; et al. Early identification of acute kidney injury in Russell’s viper (Daboia russelii) envenoming using renal biomarkers. PLoS Negl. Trop. Dis. 2019, 13, e0007486. [Google Scholar] [CrossRef] [Green Version]
- Wijewickrama, E.S.; Mohamed, F.; Gawarammana, I.B.; Endre, Z.H.; Buckley, N.A.; Isbister, G.K. Serum and urinary biomarkers for early detection of acute kidney injury following Hypnale spp. envenoming. PLoS Negl. Trop. Dis. 2021, 15, e0010011. [Google Scholar] [CrossRef]
- Chionh, C.Y.; Soni, S.S.; Finkelstein, F.O.; Ronco, C.; Cruz, D.N. Use of Peritoneal Dialysis in AKI: A Systematic Review. Clin. J. Am. Soc. Nephrol. 2013, 8, 1649–1660. [Google Scholar] [CrossRef] [PubMed] [Green Version]
- Aye, K.-P.; Thanachartwet, V.; Soe, C.; Desakorn, V.; Thwin, K.-T.; Chamnanchanunt, S.; Sahassananda, D.; Supaporn, T.; Sitprija, V. Clinical and laboratory parameters associated with acute kidney injury in patients with snakebite envenomation: A prospective observational study from Myanmar. BMC Nephrol. 2017, 18, 1–18. [Google Scholar] [CrossRef] [PubMed] [Green Version]
- Patil, T.; Bansod, Y. Snake bite-induced acute renal failure: A study of clinical profile and predictors of poor outcome. Ann. Trop. Med. Public Health 2012, 5, 335. [Google Scholar] [CrossRef]
- Than, T.; Francis, N.; Tin, N.S.; Myint, L.; Tun, P.; Soe, S.; Maung, M.O.; Phillips, R.E.; Warrell, D.A. Contribution of focal haemorrhage and microvascular fibrin deposition to fatal envenoming by Russell’s viper (Vipera russelli siamensis) in Burma. Acta Trop. 1989, 46, 23–38. [Google Scholar] [CrossRef]
- Isbister, G.; Duffull, S.; Brown, S.; for the ASP investigators. Failure of antivenom to improve recovery in Australian snakebite coagulopathy. QJM Int. J. Med. 2009, 102, 563–568. [Google Scholar] [CrossRef] [PubMed]
- Trevett, A.; Lalloo, D.; Nwokolo, N.; Naraqi, S.; Kevau, I.; Theakston, R.; Warrell, D. The efficacy of antivenom in the treatment of bites by the Papuan taipan (Oxyuranus scutellatus canni). Trans. R. Soc. Trop. Med. Hyg. 1995, 89, 322–325. [Google Scholar] [CrossRef]
- Tanos, P.; Isbister, G.; Lalloo, D.; Kirkpatrick, C.; Duffull, S. A model for venom-induced consumptive coagulopathy in snake bite. Toxicon 2008, 52, 769–780. [Google Scholar] [CrossRef]
- Theakston, R.D.; Warrell, D.A.; Griffiths, E. Report of a WHO workshop on the standardization and control of antivenoms. Toxicon 2003, 41, 541–557. [Google Scholar] [CrossRef] [PubMed]
- World Health Organization. WHO Guidelines for the Production, Control and Regulation of Snake Antivenom Immunoglobulins; World Health Organization: Geneva, Switzerland, 2016. [Google Scholar]
- Mion, G.; Larréché, S.; Benois, A.; Petitjeans, F.; Puidupin, M. Hemostasis dynamics during coagulopathy resulting from Echis envenomation. Toxicon 2013, 76, 103–109. [Google Scholar] [CrossRef]
- Isbister, G.K.; Brown, S.G.A.; Page, C.B.; McCoubrie, D.L.; Greene, S.L.; Buckley, N. Snakebite in Australia: A practical approach to diagnosis and treatment. Med. J. Aust. 2013, 199, 763–768. [Google Scholar] [CrossRef] [Green Version]
- Fox, L.; Cohney, S.J.; Kausman, J.Y.; Shortt, J.; Hughes, P.D.; Wood, E.M.; Isbel, N.M.; De Malmanche, T.; Durkan, A.; Hissaria, P.; et al. Consensus opinion on diagnosis and management of thrombotic microangiopathy in Australia and New Zealand. Intern. Med. J. 2018, 48, 624–636. [Google Scholar] [CrossRef] [Green Version]
- Morton, J.M.; George, J.N. Microangiopathic Hemolytic Anemia and Thrombocytopenia in Patients with Cancer. J. Oncol. Pract. 2016, 12, 523–530. [Google Scholar] [CrossRef]
- Bennett, C.L.; Jacob, S.; Dunn, B.L.; Georgantopoulos, P.; Zheng, X.L.; Kwaan, H.C.; McKoy, J.M.; Magwood, J.S.; Qureshi, Z.P.; Bandarenko, N.; et al. Ticlopidine-associated ADAMTS13 activity deficient thrombotic thrombocytopenic purpura in 22 persons in Japan: A report from the Southern Network on Adverse Reactions (SONAR). Br. J. Haematol. 2013, 161, 896–898. [Google Scholar] [CrossRef] [PubMed]
- Priyamvada, P.S.; Jaswanth, C.; Zachariah, B.; Haridasan, S.; Parameswaran, S.; Swaminathan, R.P. Prognosis and long-term outcomes of acute kidney injury due to snake envenomation. Clin. Kidney J. 2020, 13, 564–570. [Google Scholar] [CrossRef] [PubMed]
- Chen, T.K.; Knicely, D.H.; Grams, M.E. Chronic Kidney Disease Diagnosis and Management. JAMA J. Am. Med. Assoc. 2019, 322, 1294–1304. [Google Scholar] [CrossRef] [PubMed]
- Abboud, H.; Henrich, W.L. Stage IV Chronic Kidney Disease. N. Engl. J. Med. 2010, 362, 56–65. [Google Scholar] [CrossRef] [PubMed]
- Jokiranta, T.S. HUS and atypical HUS. Blood 2017, 129, 2847–2856. [Google Scholar] [CrossRef] [Green Version]
- Rathnayaka, R.M.M.K.N.; Ranathunga, P.E.A.N.; Kularatne, S.A.M. Thrombotic microangiopathy, hemolytic uremic syndrome and thrombotic thrombocytopenic purpura: Rare manifestations of Russell’s viper (Daboia russelii) envenoming in Sri Lanka. Asia Pac. J. Med. Toxicol. 2021, 10, 117–123. [Google Scholar] [CrossRef]
- Gando, S.; Levi, M.; Toh, C.-H. Disseminated intravascular coagulation. Nat. Rev. Dis. Prim. 2016, 2, 1–16. [Google Scholar] [CrossRef]
- Watanabe, T.; Imamura, T.; Nakagaki, K.; Tanaka, K. Disseminated Intravascular Coagulation in Autopsy Cases Its Incidence and Clinicopathologic Significance. Pathol.-Res. Pract. 1979, 165, 311–322. [Google Scholar] [CrossRef]
- Singh, B.; Hanson, A.C.; Alhurani, R.; Wang, S.; Herasevich, V.; Cartin-Ceba, R.; Kor, D.J.; Gangat, N.; Li, G. Trends in the Incidence and Outcomes of Disseminated Intravascular Coagulation in Critically Ill Patients (2004–2010). Chest 2013, 143, 1235–1242. [Google Scholar] [CrossRef] [PubMed]
- Taylor, F.; Toh, C.-H.; Hoots, K.W.; Wada, H.; Levi, M. Towards Definition, Clinical and Laboratory Criteria, and a Scoring System for Disseminated Intravascular Coagulation. Thromb. Haemost. 2001, 86, 1327–1330. [Google Scholar] [CrossRef] [PubMed] [Green Version]
- Wynick, C.; Britto, J.; Sawler, D.; Parker, A.; Karkhaneh, M.; Goodyear, D.; Sun, H.L. Validation of the Plasmic Score for Predicting ADAMTS13 Activity <10% in Patients Admitted to Hospitals in Alberta with Suspected Thrombotic Thrombocytopenic Purpura. Blood 2019, 134, 2379. [Google Scholar] [CrossRef]

| Coagulopathy Type | Toxin Mechanism of Action | Factor and Haematologic Effects | Snake Species | Common Name | Distribution | Definite TMA Reported * |
|---|---|---|---|---|---|---|
| VICC | Prothrombin activators | Fibrinogen, FII, FV, FVIII | Echis carinatus ** | Saw-scaled viper | Asia/Middle East | Yes [47] |
| Echis ocellatus ** | West African carpet viper | Africa | Yes [38] | |||
| Pseudonaja spp. | Brown snake | Australia | Yes [29] | |||
| Notechis scutatus | Tiger snake | Australia | Yes [29] | |||
| Tropidechis carinatus | Rough-scaled snake | Australia | Yes [29] | |||
| Hoplocephalus spp. | Broad-headed snakes | Australia | Yes [29] | |||
| Oxyuranus scutellatus | Coastal taipan | Australia | Yes [29] | |||
| Factor X activator | Fibrinogen | Vipera aspis | European asp/asp viper | Europe | No [30] | |
| Factor V/Factor X activators | Fibrinogen, FV, FX | Daboia russelii | Russell’s viper | Asia | Yes [15] | |
| TLEs | Fibrinogen | Hypnale spp. | Hump nosed viper | Asia | Yes [16] | |
| Atheris spp. | Bush vipers | Africa | Yes [48] | |||
| Bitis arietans | African puff adders | Africa | Yes [49] | |||
| Trimeresurus & related genera | Green pit vipers & others | Asia | No [30] | |||
| Calloselasma rhodostoma | Malayan pit viper | Asia | No [30] | |||
| Crotalus atrox | Western diamondback rattlesnake | North America | No [30] | |||
| Cerastes vipera | Sahara sand viper | Africa/Middle East | No [30] | |||
| TLEs/Other | Fibrinogen, FV | Cerastes cerastes | Saharan horned viper | Africa/Middle East | Yes [50] | |
| TLE, PTA, factor X | Fibrinogen, FII, FV, FVIII | Bothrops jararaca | Jararaca | South America | Yes [51] | |
| Anticoagulant type | Inhibitory action against FX, FII (prothrombin), and platelets | Elevated APTT | Pseudechis australis | Mulga | Australia | No [29] |
| Pseudechis porphyiacus | Red-bellied black snake | Australia | No [29] | |||
| Pseudechis spp. | Other black snakes | Australia | No [29] | |||
| Protein C activator | Unknown | Agkistrodon spp. | Southern Copperhead | North America/Central America | No [30] |
Publisher’s Note: MDPI stays neutral with regard to jurisdictional claims in published maps and institutional affiliations. |
© 2022 by the authors. Licensee MDPI, Basel, Switzerland. This article is an open access article distributed under the terms and conditions of the Creative Commons Attribution (CC BY) license (https://creativecommons.org/licenses/by/4.0/).
Share and Cite
Noutsos, T.; Currie, B.J.; Wijewickrama, E.S.; Isbister, G.K. Snakebite Associated Thrombotic Microangiopathy and Recommendations for Clinical Practice. Toxins 2022, 14, 57. https://doi.org/10.3390/toxins14010057
Noutsos T, Currie BJ, Wijewickrama ES, Isbister GK. Snakebite Associated Thrombotic Microangiopathy and Recommendations for Clinical Practice. Toxins. 2022; 14(1):57. https://doi.org/10.3390/toxins14010057
Chicago/Turabian StyleNoutsos, Tina, Bart J. Currie, Eranga S. Wijewickrama, and Geoffrey K. Isbister. 2022. "Snakebite Associated Thrombotic Microangiopathy and Recommendations for Clinical Practice" Toxins 14, no. 1: 57. https://doi.org/10.3390/toxins14010057
APA StyleNoutsos, T., Currie, B. J., Wijewickrama, E. S., & Isbister, G. K. (2022). Snakebite Associated Thrombotic Microangiopathy and Recommendations for Clinical Practice. Toxins, 14(1), 57. https://doi.org/10.3390/toxins14010057

